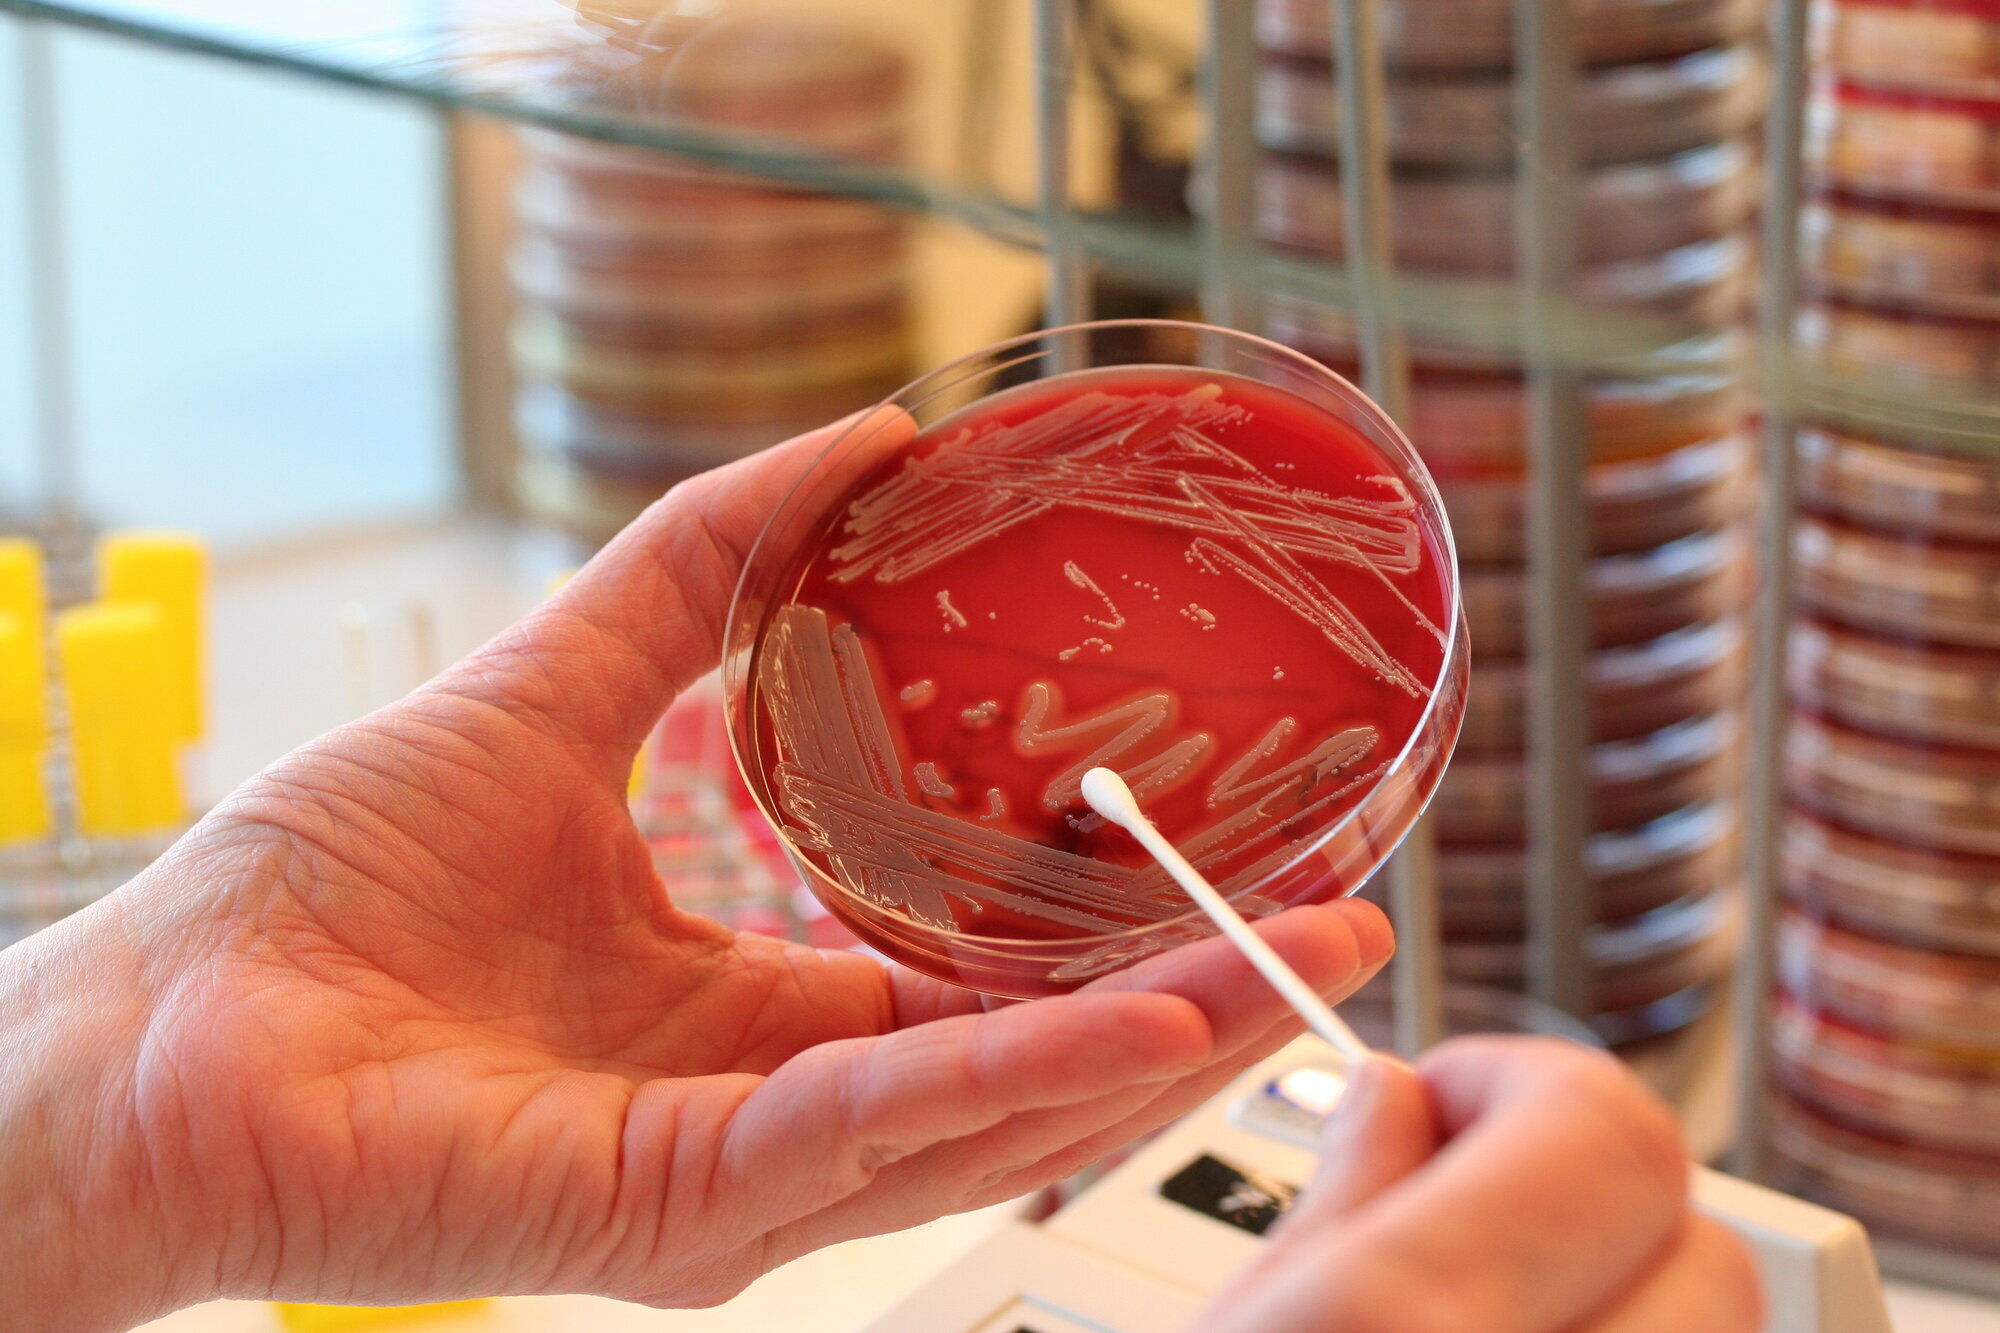

Best til å gi mindre antibiotika

«Er det rette kuren?» Med slike spørsmål til legen kan sykepleierne begrense bruken av antibiotika, mener hygienesykepleier Unni Fosse.
Voss sykehus har vært best i klassen, melder Helse Bergen. Det vil si flinkest til å bruke mindre antibiotika.
Siden 2012 har sykehuset redusert bruken av bredspektret antibiotika med 35 prosent. Dermed er det nasjonale målet nådd fire år før «fristen».
Det nasjonale målet er nemlig å redusere antibiotikabruken i befolkningen med 30 prosen t innen utløpet av 2020. Dette ifølge Handlingsplan mot antibiotikaresistens.
Klarer neppe å redusere mer
– Vi tror ikke at vi kunne klart å redusere bruken av bredspektrede særlig mer. Pasientene skal jo ha rett behandling, sier Unni Fosse, som er hygienesykepleier på Haukeland sykehus, men hun har jobbet mye på Voss sykehus, som også hører til under Helse Bergen.
Fosse er del av antibiotikateamet som ble dannet i 2015, bestående av leger, sykepleiere og farmasøyt.
Sykehus bruker bredspektret
– Legegruppen sa hvor det var mest nærliggende å redusere. De mente at vi kunne stramme inn på bruken av 3. generasjons cefalosporiner, som er bredspektret.
Antibiotikaforbruket i sykehus utgjør bare 8 prosent av totalforbruket i Norge, ifølge handlingsplanen.
Men det er sykehus som bruker mest av de bredspektrede antibiotikaene. Siden 1990-tallet har det vært en mangedobling i bruken.
– Sykepleierne er viktige
Tallene for antibiotikabruk på Voss sykehus er basert på det sykehuset har kjøpt inn fra apotek:
– Når vi får elektronisk kurve på plass, vil vi kunne hente ut enda mer presise tall over hvilken type antibiotika som brukes og over hvor lang tid, sier hygienesykepleier Unni Fosse.
Sykepleierne blir viktige i dette arbeidet, selv om det ikke er de som forskriver, mener hun:
– De kan være med på å begrense bruken. De kan spørre legen: «Hvorfor velge bredspektret? Kan man bruke smalspektret antibiotika til denne pasienten?» De kan også være med på å sikre at det blir tatt mikrobiologiske prøver før man starter antibiotikakuren.
Jo tidligere man får tatt mikrobiologiske prøver, jo raskere kan man smalne inn antibiotikakuren, påpeker Fosse.
– Slik kan man få mer målrettet behandling.

Spørre legen
Antibiotikabruken skal revurderes innen 72 timer etter oppstart:
– Sykepleierne kan bidra ved å spørre legene om det fortsatt er indikasjon for antibiotika, og om det er den rette kuren. Sykepleierne er tett på pasientene og kan observere om behandlingen har effekt, sier Fosse.
Sykepleierne kan også foreslå overgang fra intravenøs til peroral administrering når pasienten er stabil.
Legene på Voss tåler å bli spurt
På Voss sykehus skal kortversjonen av antibiotikaretningslinjene være tilgjengelig ved alle pc-er på legekontor og vaktrom, forteller Fosse.
Slik blir det lettere å velge rett behandling. Det informeres blant annet om hvilke antibiotika som er bredspektret og hvilke som er smalspektret.
– Vi prøver å få opp kunnskapen om antibiotika og resistens blant sykepleiere. Mange kan mye, men en del er også usikre. De må også forstå prøvesvarene fra mikrobiologen, sier Fosse.
Temaet tas opp på møter og i undervisningen
Fosse påpeker at forholdet mellom leger og sykepleiere er godt på sykehuset på Voss.
– Leger oppfatter ikke at sykepleierne blander seg inn når de stiller spørsmål.
Barn og kvinner får unødvendig antibiotika
– Resistente bakterier er et stadig tema i mediene?
– Ja, dette er et viktig tema for befolkningen også.
Størstedelen av antibiotikabruken skjer utenfor sykehusene. Fastlegene er de som skriver ut mest.
Antibiotika brukes ofte unødvendig, spesielt ved luftveisinfeksjoner hos barn og ved urinveisinfeksjoner hos kvinner, ifølge den nasjonale handlingsplanen.
– Det er viktig at vi som privatpersoner ikke forlanger antibiotika i tide og utide. Antibiotika hjelper jo ikke mot virusinfeksjoner. Men folk har ikke tid til å være syk, ikke ungene heller, sier Fosse.
Hun presiserer at de som trenger antibiotika, skal få behandling.
Har resistente tarmbakterier uten at de vet det
– Er du selv bekymret for økningen av resistente bakterier?
– Stadig flere pasienter blir bærere av resistente tarmbakterier uten at de nødvendigvis er syke, og uten at de er klar over det. Utfordringen i helseinstitusjoner er å unngå at smitten sprer seg.
– Da er vi tilbake til grunnleggende smittevern – som god håndhygiene og adekvate rutiner for rengjøring og desinfeksjon av kontaktpunkt og fellesutstyr, påpeker hygienesykepleieren.
Tallene kan svinge fra år til år
– Hva vil du si til andre som vil bruke mindre antibiotika?
– Når man etablerer team, er det lurt å finne dem som er engasjert. Og la så temaet selv finne ut hvor det er mulig å få til endringer. Arbeidet må også forankres i ledelsen, slik at det for eksempel blir satt av nok tid til møter, sier Fosse.
– Er de nasjonale målene for puslete, siden dere nådde dem så raskt?
– Vi kan neppe redusere så mye mer, men vi skal jobbe for å holde forbruket på det lave nivået vi nå har nådd. På et lite sykehus er det nok at bare noen få pasienter trenger langvarig behandling med bredspektret antibiotika – så kan tallene våre gå opp igjen.
Fosse forteller at legene Gro N. Riise og Arjan Kuiper på Voss sykehus har laget antibiotikavettreger.
– Disse har slått så godt an at de er blitt delt nasjonalt, forteller Unni Fosse.
Her er de, fritt etter fjellvettreglene::
Liten oversikt på sykehjem
Forbruket av antibiotika i sykehjem overvåkes i dag ikke systematisk.
Ifølge den nasjonale handlingsplanen er det holdepunkter for at:
- Antibiotikabruken i norske sykehjem varierer betydelig.
- En vesentlig del av den antibiotika som foreskrives er ikke i tråd med gjeldende retningslinjer.
I sykehjem blir antibiotika hyppigst brukt til forebygging og behandling av urinveisinfeksjoner (43 prosent) og behandling av luftveisinfeksjoner (31 prosent), ifølge handlingsplanen.
Der står det også at en punktprevalensstudie fra 2006 viste at hele 10 prosent av alle sykehjemsbeboere fikk antibiotika profylaktisk. Altså forebyggende.
LES OGSÅ Mirakelets tid er nesten forbi







0 Kommentarer